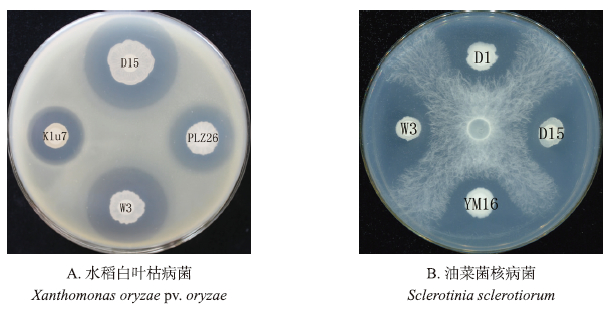
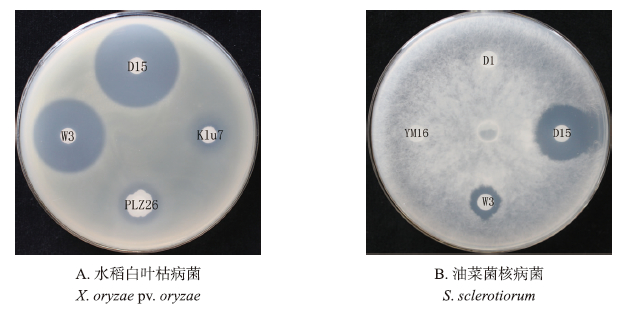

文章信息
- 林玲, 伍辉军, 梁文伯, 高学文. 2016.
- LIN Ling, WU Huijun, LIANG Wenbo, GAO Xuewen. 2016.
- 马来西亚植物根际土壤芽孢杆菌的鉴定及其对水稻白叶枯病防治效果
- Identification of the Bacillus spp. strains isolated from Malaysia plant rhizosphere soil and their control effects against rice bacterial leaf blight
- 南京农业大学学报, 39(3): 394-401
- Journal of Nanjing Agricultural University, 39(3): 394-401.
- http://dx.doi.org/10.7685/jnau.201509009
-
文章历史
- 收稿日期:2015-09-07
芽孢杆菌(Bacillus spp.)是植物根围促生细菌(plant growth promoting rhizobacteria,PGPR)研究领域的典型代表。这类细菌具有高效利用种子和根系渗出物,快速生长繁殖,有效定殖在植物根际,产生多类活性代谢物质等优点。而且这类细菌还能形成抗逆性强的芽孢,适合产业化生产[1]。目前,部分菌株已经商业化应用于植物病害生物防治,如GB03[2]和MBI600[3]等。拜耳公司开发的2种芽孢杆菌类生物杀菌剂产品Kodiak® Concentrate和Yield Shield® Concentrate Biological Fungicides,对镰刀菌属(Fusarium spp.)和丝核菌属(Rhizoctonia spp.)等植物病原真菌有很好的防治效果。在国内,商品化的菌株有B3、B903和B916等[4]。其中,利用B3菌株开发的“麦丰宁”对小麦纹枯病具有较好的防治效果[5],B916与井冈霉素的复配制剂“纹曲宁”对水稻纹枯病和稻曲病具有较好的防治效果[6]。开发此类微生物杀菌剂的关键是获得优异的菌株资源。迄今为止,研究人员从各种生境如植物根围土壤中分离和鉴定到大量的芽孢杆菌菌株[3]。这些从不同生境中得到的芽孢杆菌存在较大差异,如刘芳等[7]从西藏植物根围土壤中获得了能在低温下生长,并且高效促生和防病的芽孢杆菌菌株。因此,对不同生境中的芽孢杆菌进行研究,一方面能丰富芽孢杆菌菌株的种类,另一方面能为微生物制剂的研发提供优异的菌株资源。
芽孢杆菌能产生丰富的抗菌物质,包括脂肽类、聚酮类、肽类、磷脂类和多烯类等,这些物质在防治植物病害中起着重要作用[8]。其中,最典型的是通过非核糖体途径合成的脂肽类抗生素(lipopeptides),包括表面活性素(Surfactin)、伊枯草菌素(Iturin)和泛革素(Fengycin)3类。Surfactin具有抑制病毒和细菌活性,还对细菌的群集运动(Swarming)以及生物膜的形成起着重要作用[9, 10, 11]。Iturin具有很强的抑制真菌的活性,以及有限的抑制病毒和细菌的能力[12]。Fengycin则对丝状真菌具有很强的抑制效果[9]。活性物质的鉴定和相关机制的研究是芽孢杆菌类生物农药的重要理论基础。
本研究拟从马来西亚怡宝和太平地区不同植物根围土样中分离鉴定抑菌活性强的芽孢杆菌菌株。马来西亚气候属于典型的热带雨林和热带季风气候。在该地区植物根际中的芽孢杆菌菌株可能具有典型的地域特征。本研究通过筛选获得了6株对油菜菌核病菌(Sclerotinia sclerotiorum)或水稻白叶枯病菌(Xanthomonas oryzae pv.oryzae)具有很强抑制活性的芽孢杆菌菌株,利用16S rDNA和gyrB基因序列对这些菌株进行分类鉴定,采用MALDI-TOF-MS分析菌株所产生的脂肽类抗生素的种类。同时,本研究还对菌株防治水稻白叶枯病的效果进行研究,旨在为生物农药的开发提供宝贵的芽孢杆菌菌株资源。
1 材料与方法 1.1 供试菌株及培养基芽孢杆菌菌株分离自马来西亚不同地区植物根围土壤;油菜菌核病菌(Sclerotinia sclerotiorum)JK19菌株及水稻白叶枯病菌(Xanthomonas oryzae pv.oryzae)PXO99A菌株由南京农业大学植物保护学院生物防治及细菌分子实验室保存。芽孢杆菌培养采用LB培养基;芽孢杆菌发酵培养基为Landy培养基[13];水稻白叶枯病菌在NA培养基中培养;油菜菌核病菌在PDA培养基中培养。
1.2 拮抗芽孢杆菌的筛选采用平板对峙法检测芽孢杆菌的抑菌活性,筛选抑菌效果较好的芽孢杆菌菌株,病原指示细菌为水稻白叶枯病菌PXO99A菌株,病原指示真菌为油菜菌核病菌JK19菌株。
1.2.1 对水稻白叶枯病菌拮抗活性的检测将水稻白叶枯病菌培养液按一定比例(1:30)加入冷却到50 ℃左右的NA培养基中混匀,制成含菌平板,在距离中心2.5 cm处“十”字型放置4个直径为4 mm的滤纸片,吸取芽孢杆菌菌株培养液10 μL,接种于滤纸片上,置于28 ℃培养箱培养2~3 d,观察并记录平板对峙试验中抑菌圈的直径大小情况。每个处理重复3次。
1.2.2 对油菜菌核病菌拮抗活性的检测先用PDA培养基,在26 ℃培养箱中,活化油菜菌核病菌。在菌落边缘打取直径为0.7 cm的菌碟(取指示菌边缘生长旺盛的菌丝块),接种在新的PDA平板中央。在距离菌块2.5 cm处,呈“十”字型分布的4个接种点,放上直径4 mm的滤纸小圆片,取芽孢杆菌菌株培养液10 μL,接种在滤纸片中央,放入26 ℃恒温培养箱中培养2~3 d后,取出观测并记录抑菌圈直径大小情况。每个处理重复3次。
1.3 分离菌株的分子鉴定对筛选出的具有较强抑菌活性的芽孢杆菌菌株进行分子鉴定。分别扩增和获得16S rDNA和gyrB基因序列,并利用序列构建系统发育进化树。16S rDNA基因扩增引物分别为:Forward primer 27F:5′-AGAG-TTTGATCMTGGCTCAG-3′;Reverse primer 1492R:5′-GGYTACCTTGTTACGACTT-3′。gyrB基因扩增引物分别为:Forward primer UP2r:5′-AGCAGGGTACGGATGTGCGAGCCRTCNACRTCNGCRTCNGTCAT-3′;Reverse primer UP1:5′-GAAGTCATCATGACCGTTCTGCAYGCNGGNGGNAARTTYGA-3′。PCR扩增反应试剂购自TaKaRa公司,参照标准建立PCR反应体系。引物合成和序列测定均由南京金斯瑞生物技术有限公司完成。所获序列先利用NCBI进行BLAST分析,再利用MEGA 3.1软件构建系统发育树。
1.4 脂肽类抗生素的提取和抑菌活性以及组分分析脂肽类抗生素的提取参考本实验室王帅等[14]的方法。脂肽类抗生素的抑菌活性分析参照上述活菌拮抗试验的方法。
脂肽类抗生素组分分析采用基质协助激光解吸附/电离-飞行时间质谱(matrix-assisted laser desorption/ionization-time of fligh mass spectrometry,MALDI-TOF-MS)法进行检测[8],基质为α-氰-4-羟肉桂酸(α-cyano-4-hydroxycinnamic acid)。
1.5 盆栽试验防治效果供试水稻材料为‘南梗46’。将水稻种子放在底部垫有湿润滤纸的有盖玻璃平板中,置于26 ℃光照培养箱中催芽。待水稻芽长达1~2 cm时移苗,待水稻分蘖至4~5叶时,喷施108 CFU·mL-1芽孢杆菌培养液5 mL。7 d后向喷施过芽孢杆菌的水稻苗剪叶接种108 CFU·mL-1水稻白叶枯病菌,接种14 d后调查水稻叶片上的病斑长度。采用LB培养基为空白对照[15],每个处理调查10株水稻苗,每株3片叶片,每个处理重复3次。应用SPSS 16.0软件进行数据统计分析。
2 结果与分析 2.1 芽孢杆菌菌株的抑菌活性检测抑菌活性筛选结果表明:从马来西亚植物根围土壤中分离得到的芽孢杆菌菌株D15、W3、Klu7、YM16、D1和PLZ26对水稻白叶枯病菌或油菜菌核病菌有抑菌作用,其中菌株D15、Klu7、PLZ26和W3对水稻白叶枯病菌PXO99A具有较强的抑制活性(图 1-A),平均抑制直径都在20.0 mm以上。其中,菌株D15抑菌活性最强,其抑菌直径达到了33.9 mm,与其他3株菌株之间差异显著(表 1)。
|
图 1 芽孢杆菌活菌的抑菌情况 Fig. 1 The inhibitory activity of different Bacillus spp. |
| 菌株Strains | 菌液抑菌直径/mmDiameters of zones of inhibition by liquid | 脂肽类抗生素抑菌直径/mmDiameters of zones of inhibition by lipopeptide | ||
| 水稻白叶枯病菌X.oryzae pv.oryzae | 油菜菌核病菌S.sclerotiorum | 水稻白叶枯病菌X.oryzae pv.oryzae | 油菜菌核病菌S.sclerotiorum | |
| D1 | — | 24.1±0.1d | — | — |
| D15 | 33.9±0.1a | 32.7±0.2a | 32.2±0.7a | 20.8±0.3 |
| W3 | 29.9±0.1b | 31.2±0.1b | 27.8±0.4b | 11.8±0.2 |
| YM16 | — | 26.3±0.2c | — | — |
| PLZ26 | 23.7±0.1c | — | 13.9±0.8c | — |
| Klu7 | 21.5±0.3d | — | 14.5±1.8c | — |
| 注:同列不同小写字母表示在0.05水平差异显著。 Note:Different lowercases in the same column stand for significant difference at 0.05 level. |
||||
菌株D1、D15、YM16和W3对油菜菌核病菌JK19都具有较强的抑制活性,其平均抑菌直径都在24.0 mm以上。其中,菌株D15抑菌活性最强,抑菌直径达到了32.7 mm,与其他3株菌株差异达到了显著水平(图 1-B,表 1)。有趣的是,菌株D15和W3对水稻白叶枯病菌和油菜菌核病菌都具有显著的抑菌效果,且抑菌活性较强(表 1)。我们推测这2株菌株能同时产生抑制真菌和细菌的活性物质。
2.2 利用16S rDNA和gryB基因序列对芽孢杆菌菌株进行分类鉴定利用16S rDNA的通用引物,以D15、W3、Klu7、YM16、D1和PLZ26的基因组DNA为模板,进行PCR扩增,均能得到大小约1 500 bp的条带,与芽孢杆菌16S rDNA的理论值基本相符。测序后,利用NCBI的BLAST分析,发现这6株菌株的16S rDNA与已报道的芽孢杆菌菌株的序列同源性都在99%以上,说明这些菌株都属于芽孢杆菌属细菌。选择全基因组已知的芽孢杆菌模式菌株构建系统发育树,结果表明:菌株D15和W3与解淀粉芽孢杆菌(B.amyloliquefaciens)FZB42、NAU-B3和SQR9聚合在同一分支,说明这2株菌株与解淀粉芽孢杆菌亲缘关系相对较近;菌株Klu7与短小芽孢杆菌(B.pumilus)模式菌株SAFR-032和MTCC B6033位于同一分支,基本可以确定该菌株属于短小芽孢杆菌;而菌株YM16、D1和PLZ26则与苏云金芽孢杆菌(B.thuringiensis)和蜡样芽孢杆菌(B.cereus)聚合在一个大的分支,这说明采用16S rDNA构建进化树,无法有效地将苏云金芽孢杆菌与蜡样芽孢杆菌区别开来,需要利用其他方法进一步鉴定。

|
图 2 基于16S rDNA序列构建的系统发育树 Fig. 2 Phylogenetic tree of Bacillus strains based on 16S rDNA gene sequences |
许多研究表明利用gryB基因序列构建进化树,能将芽孢杆菌鉴定到种以下分类单元[16]。在本研究中,我们也采用了同样的方法,对菌株进行进一步鉴定。结果表明:利用gryB的通用引物进行PCR扩增,能得到1 200 bp的条带,与芽孢杆菌gryB的理论值基本相符。利用NCBI的BLAST对序列进行初步分析,结果表明这6株菌株的序列与芽孢杆菌属细菌的同源性最高能达到100%。系统发育树分析表明:D15和W3与3株解淀粉芽孢杆菌聚合在一个分支,这与16S rDNA的分析结果相一致,表明D15和W3菌株属于解淀粉芽孢杆菌。同样,菌株Klu7与短小芽孢杆菌位于同一分支,也与16S rDNA分析的结果一致,说明菌株Klu7属于短小芽孢杆菌。而采用gryB系统发育分析之后,则能将苏云金芽孢杆菌与蜡样芽孢杆菌很好地区别开来,从图 3可以看出,菌株D1和PLZ26属于苏云金芽孢杆菌,菌株YM16属于蜡样芽孢杆菌。

|
图 3 基于gyrB基因序列构建的系统发育树 Fig. 3 Phylogenetic tree of Bacillus strains based on gyrB gene sequences |
对6株菌株的脂肽类粗提物的抑菌活性分析结果(图 4)表明:菌株D15和W3的粗提物同时具有抑制水稻白叶枯病菌和油菜菌核病菌的活性,这与活菌拮抗活性结果相一致。脂肽类抗生素质谱图分析 表明,这2株菌株能产生典型的Iturin A的m/z值,如1 065.438、1 079.455和1 093.479等(表 2)。菌株
|
图 4 芽孢杆菌脂肽类抗生素的抑菌活性检测 Fig. 4 The inhibitory activity of lipopeptides produced by different Bacillus spp. |
| 产物类型和质谱峰值Product and observed mass peaks(m/z) | 峰的结构鉴定Peak assignment |
| Surfactin | |
| 1 058.6*···································································································································· | C15-Surfactin[M+Na]+ |
| 1 072.6*,1 088.6*························································································································ | C16-Surfactin[M+Na,K]+ |
| Iturin A | |
| 1 065.5*,1 081.5*························································································································ | C14-Iturin A[M+Na,K]+ |
| 1 079.5*,1 095.5*························································································································ | C15-Iturin A[M+Na,K]+ |
| 1 093.5*,1 109.5*························································································································ | C16-Iturin A[M+Na,K]+ |
| Bacillomycin D | |
| 1 053.5*,1 069.4*························································································································ | C14-Bacillomycin D[M+Na,K]+ |
| 1 067.5*,1 083.5*························································································································ | C15-Bacillomycin D[M+Na,K]+ |
| 1 081.5*,1 097.5*························································································································ | C16-Bacillomycin D[M+Na,K]+ |
| 1 095.5*,1 111.5*························································································································ | C17-Bacillomycin D[M+Na,K]+ |
PLZ26和Klu7的脂肽类粗提物具有抑制水稻白叶枯病菌的活性,这也与其活菌的拮抗活性一致,质谱分析表明,这2株菌株都能产生Surfactin(图 5-A)。有趣的是,菌株D1和YM16的粗提物则不具有活菌那样的抑制真菌的活性,而质谱分析表明这2株菌株能分别产生Iturin 家族中的Iturin A和Bacillomycin D(图 5-B),而对这2株菌株的质谱图深入分析表明,这2株菌株的Iturin A和Bacillomycin D的丰度不足D15和W3的1/10(图 5-B,C,D),说明这2株菌株这类物质产量很低,导致其相应提取物达不到有效作用浓度,而活菌之所以具有抑菌活性,我们推测活菌能产生非脂肽类的具有抑制真菌活性的物质。

|
图 5 芽孢杆菌菌株产生的脂肽类抗生素的MALDI-TOF-MS检测 Fig. 5 MALDI-TOF-MS analysis of lipopeptides produced by Bacillus strains |
上述结果表明,菌株D15、Klu7、PLZ26和W3的活菌和脂肽类抗生素都具有抑制水稻白叶枯病菌的活性。因此,我们对这4株菌株防治水稻白叶枯病的生防效果进行了检测。结果表明:菌株PLZ26处理后,病斑长度为81.0 mm,与模式菌株FZB42的效果相当,与对照病斑平均长度(117.3 mm)差异显著。表明该菌株防治水稻白叶枯病效果较好。菌株D15、Klu7及W3处理后,平均病斑长度为102.7~117.7 mm,与对照差异不显著,其中菌株W3的防治效果最差。

|
图 6 芽孢杆菌菌株对水稻白叶枯病的防治效果 Fig. 6 The biocontrol effect on rice bacterial leaf blight of Bacillus spp. strains *表示有显著性差异(P<0.05)。* means the significant difference(P<0.05). |
一些芽孢杆菌属细菌属于植物根围促生细菌(plant growth promoting rhizobacteria,PGPR),其能成功定殖到植物根际、体表或体内,与病原菌竞争生存空间和营养物质,还能分泌抗菌物质以抑制病原菌生长,同时诱导植物产生系统抗性抵御病原菌入侵,从而起到生防作用[17]。因此,挖掘这类有益芽孢杆菌菌株资源,是开发此类微生物农药的基础。本研究主要目的是从马来西亚植物根围土样中,分离和鉴定具有高抑菌活性的芽孢杆菌菌株。在菌株鉴定过程中,我们发现表型及生理生化特征的检测只能将菌株鉴定到属,而同时采用了16S rDNA和gyrB基因序列进行分类鉴定,则能将菌株鉴定到种。Kasai等[18]的研究结果也表明在微生物亲缘关系较近时,16S rDNA序列分析会有一些局限性,而gyrB基因序列分析相对于16S rDNA基因具有较高的区分度,适合亲缘关系较近菌种的鉴定。
生防芽孢杆菌能产生3类典型的脂肽类抗生素,Surfactin、Iturin和Fengycin。这3类物质都具有一定的抑菌活性,在防治植物病害中起着重要作用。MALDI-TOF-MS分析表明,菌株PLZ26和Klu7能产生具有抑制细菌的Surfactin,其活菌则具有较强的拮抗细菌的活性。而菌株D15和W3能产生Iturin,其活菌则既具有拮抗细菌的活性,同时还能抑制真菌。这说明这些芽孢杆菌产生的脂肽类物质在其拮抗活性中起着重要作用。而苏云金芽孢杆菌D1和蜡样芽孢杆菌YM16菌株的脂肽类物质的抑菌活性则与活菌的不一致,质谱检测表明这2株菌株的Iturin产量相对较低。我们推测由于这2株菌株产生的Iturin无法达到有效抑制浓度,而活菌可能分泌非脂肽类抗菌物质,从而具有拮抗真菌的活性。已有研究表明,这2类菌株确实能产生非脂肽类抗菌物质[19, 20]。因此,对这2株菌株进行深入研究,一方面能了解脂肽类物质的调控机制,另一方面有助于发现新的抗菌物质。
本试验菌株防治水稻白叶枯病的结果表明,菌株PLZ26和Klu7都能产生抑制细菌的物质Surfactin,但在防治效果上存在显著差异。我们推测,导致这种差异的原因可能是菌株在植物根部和叶部定殖能力的不同。已有多篇研究报道表明,芽孢杆菌防治植物病害中,产生的抗菌物质起着很重要的作用,但菌株生物膜的形成、定殖能力的差异等也起着决定性的作用[21, 22]。因此,开展后续相关的研究工作,有助于深入了解芽孢杆菌防治植物病害的机制。
| [1] | Falardeau J,Wise C,Novitsky L,et al. Ecological and mechanistic insights into the direct and indirect antimicrobial properties of Bacillus subtilis lipopeptides on plant pathogens[J]. Journal Chemical Ecology,2013,39(7):869-878. |
| [2] | Choi S-K,Jeong H,Kloepper J,et al. Genome sequence of Bacillus amyloliquefaciens GB03,an active ingredient of the first commercial biological control product[J]. Genome Announcements,2014,2(5):e01092-14. |
| [3] | Vijay K K,Yellareddygari S K,Reddy M S,et al. Efficacy of Bacillus subtilis MBI600 against sheath blight caused by Rhizoctonia solani and on growth and yield of rice[J]. Rice Science,2012,19(1):55-63. |
| [4] | 陈志谊,刘永锋,刘邮洲,等. 植物病害生防芽孢杆菌研究进展[J]. 江苏农业学报,2012,28(5):999-1006. Chen Z Y,Liu Y F,Liu Y Z,et al. Research progress in biocontrol of Bacillus spp. against plant diseases[J]. Jiangsu Journal of Agricultural Sciences,2012,28(5):999-1006(in Chinese with English abstract). |
| [5] | 张学君,凌宏通,王金生,等. 生物农药麦丰宁B3对小麦纹枯病菌的抑制作用[J]. 植物病理学报,1994,24(4):361-366. Zhang X J,Ling H T,Wang J S,et al. Biological pesticides maifengning B3 can inhibit rice sheath blight disease[J]. Acta Phytopathologica Sinica,1994,24(4):361-366(in Chinese). |
| [6] | 顾中言,唐为爱,陈志谊,等. 表面活性剂对生物农药纹曲宁抑菌活性和防病效果的影响[J]. 江苏农业学报,2005,21(3):162-166. Gu Z Y,Tang W A,Chen Z Y,et al. Influence of surfactants on fungicidal activity and control efficacy against rice sheath blight of the bio-pesticide wenquning[J]. Jiangsu Journal of Agricultural Sciences,2005,21(3):162-166(in Chinese with English abstract). |
| [7] | 刘芳,薛鹏琦,乔俊卿,等. 西藏低温适生芽孢杆菌的分离鉴定及其抗菌和促生作用[J]. 中国生物防治,2010,26(4):453-460. Liu F,Xue P Q,Qiao J Q,et al. Isolation and identification of a low-temperature-adapted Bacillus in Tibet and its antagonistic and growth-promoting effect[J]. Chinese Journal of Biological Control,2010,26(4):453-460(in Chinese with English abstract). |
| [8] | Ongena M,Jacques P. Bacillus lipopeptides:versatile weapons for plant disease biocontrol[J]. Trends in Microbiol,2008,16(3):115-125. |
| [9] | Stein T. Bacillus subtilis antibiotics:structures,syntheses and specific functions[J]. Molecular Microbiology,2005,56:845-857. |
| [10] | Bais H P,Fall R,Vivanco J M. Biocontrol of Bacillus subtilis against infection of Arabidopsis roots by Pseudomonas syringae is facilitated by biofilm formation and surfactin production[J]. Plant Physiology,2004,134(1):307-319. |
| [11] | Kearns D B,Chu F,Rudner R,et al. Genes governing swarming in Bacillus subtilis and evidence for a phase variation mechanism controlling surface motility[J]. Molecular Microbiology,2004,52(2):357-369. |
| [12] | Magetdana R,Peypoux F. Iturins,a special class of pore-forming lipopeptides:biological and physicochemical properties[J]. Toxicology,1994,87(1/2/3):151-174. |
| [13] | Wei Y H,Chu I M. Enhancement of surfactin production in iron-enriched media by Bacillus subtilis ATCC21332[J]. Enzyme and Microbial Technology,1998,22:724-728. |
| [14] | 王帅,高圣风,高学文,等. 枯草芽孢杆菌脂肽类抗生素发酵和提取条件[J]. 中国生物防治,2007,23(4):342-347. Wang S,Gao S F,Gao X W,et al. Fermentation optimization in lipopeptide prouctivity of Bacillus subtilis G1[J]. Chinese Journal of Biological Control,2007,23(4):342-347(in Chinese with English abstract). |
| [15] | 刘永锋,陆凡,陈志谊,等. 拮抗细菌T429和T392的生物活性及其对水稻白叶枯病的防治效果[J]. 江苏农业学报,2012,28(4):733-737. Liu Y F,Lu F,Chen Z Y,et al. Biological activities of antagonistic bacterial isolates T429 and T392 and their control effects against rice bacterial leaf blight(Xanthomonas oryzae)[J]. Jiangsu Journal of Agricultural Sciences,2012,28(4):733-737(in Chinese with English abstract). |
| [16] | Caamano A S,Fernandez N I C,Bohme K M,et al. Genetic discrimination of foodborne pathogenic and spoilage Bacillus spp. based on three housekeeping genes[J]. Food Microbiology,2015,46:288-298. |
| [17] | Kloepper J W,Ryu C M,Zhang S A,et al. Induced systemic resistance and promotion of plant growth by Bacillus spp.[J]. Phytopathology,2004,94(11):1259-1266. |
| [18] | Kasai H,Ezaki T,Harayama S. Differentiation of phylogenetically related slowly growing mycobacteria by their gyrB sequences[J]. Journal of Clinical Microbiology,2000,38(1):301-308. |
| [19] | 李云,杨胜远,林晓东,等. 产细菌素苏云金芽孢杆菌的鉴定及其所产抗菌物质性质[J]. 食品科学,2010,31(11):147-152. Li Y,Yang S Y,Lin X D,et al. Identification of bacteriocin-producing Bacillus thuringiensis and properties of its antibacterial substances[J]. Food Science,2010,31(11):147-152(in Chinese with English abstract). |
| [20] | 张立娜. 一株蜡样芽孢杆菌的鉴定及其抑菌物质的分离纯化与性质的研究[D]. 广州:华南理工大学,2012:37-38. Zhang L N. Identification of a Bacillus cereus and isolation and study on its antimicrobial substance[D]. Guangzhou:South China University of Technology,2012:37-38(in Chinese with English abstract). |
| [21] | Gao S F,Wu H J,Wang W D,et al. Efficient colonization and harpins mediated enhancement in growth and biocontrol of wilt disease in tomato by Bacillus subtilis[J]. Letters in Applied Microbiology,2013,57(6):526-533. |
| [22] | Chen Y,Yan F,Chai Y R,et al. Biocontrol of tomato wilt disease by Bacillus subtilis isolates from natural environments depends on conserved genes mediating biofilm formation[J]. Environmental Microbiology,2013,15(3):848-864. |




